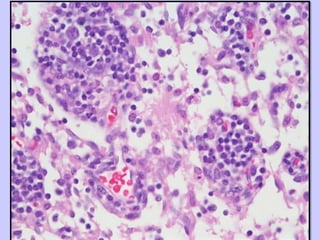
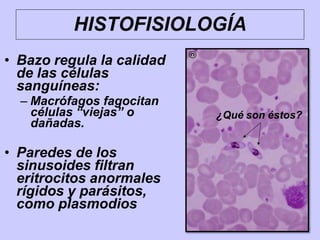
• Bazo regula la calidad
de las células
sanguíneas:
– Macrófagos fagocitan
células “viejas” o
dañadas.
• Paredes de los
sinusoides filtran
eritrocitos anormales
rígidos y parásitos,
como plasmodios
HISTOFISIOLOGÍA
¿Qué son éstos?

El documento resume la histología del tejido linfoide, ganglios linfáticos, timo y bazo. Los ganglios linfáticos tienen una cápsula, trabéculas y están divididos en corteza y médula. La corteza contiene nódulos linfoides primarios y secundarios, mientras que la médula contiene cordones medulares. El timo contiene linfocitos T y diferentes tipos de células epiteliales en la corteza y médula. El bazo filtra la sangre y